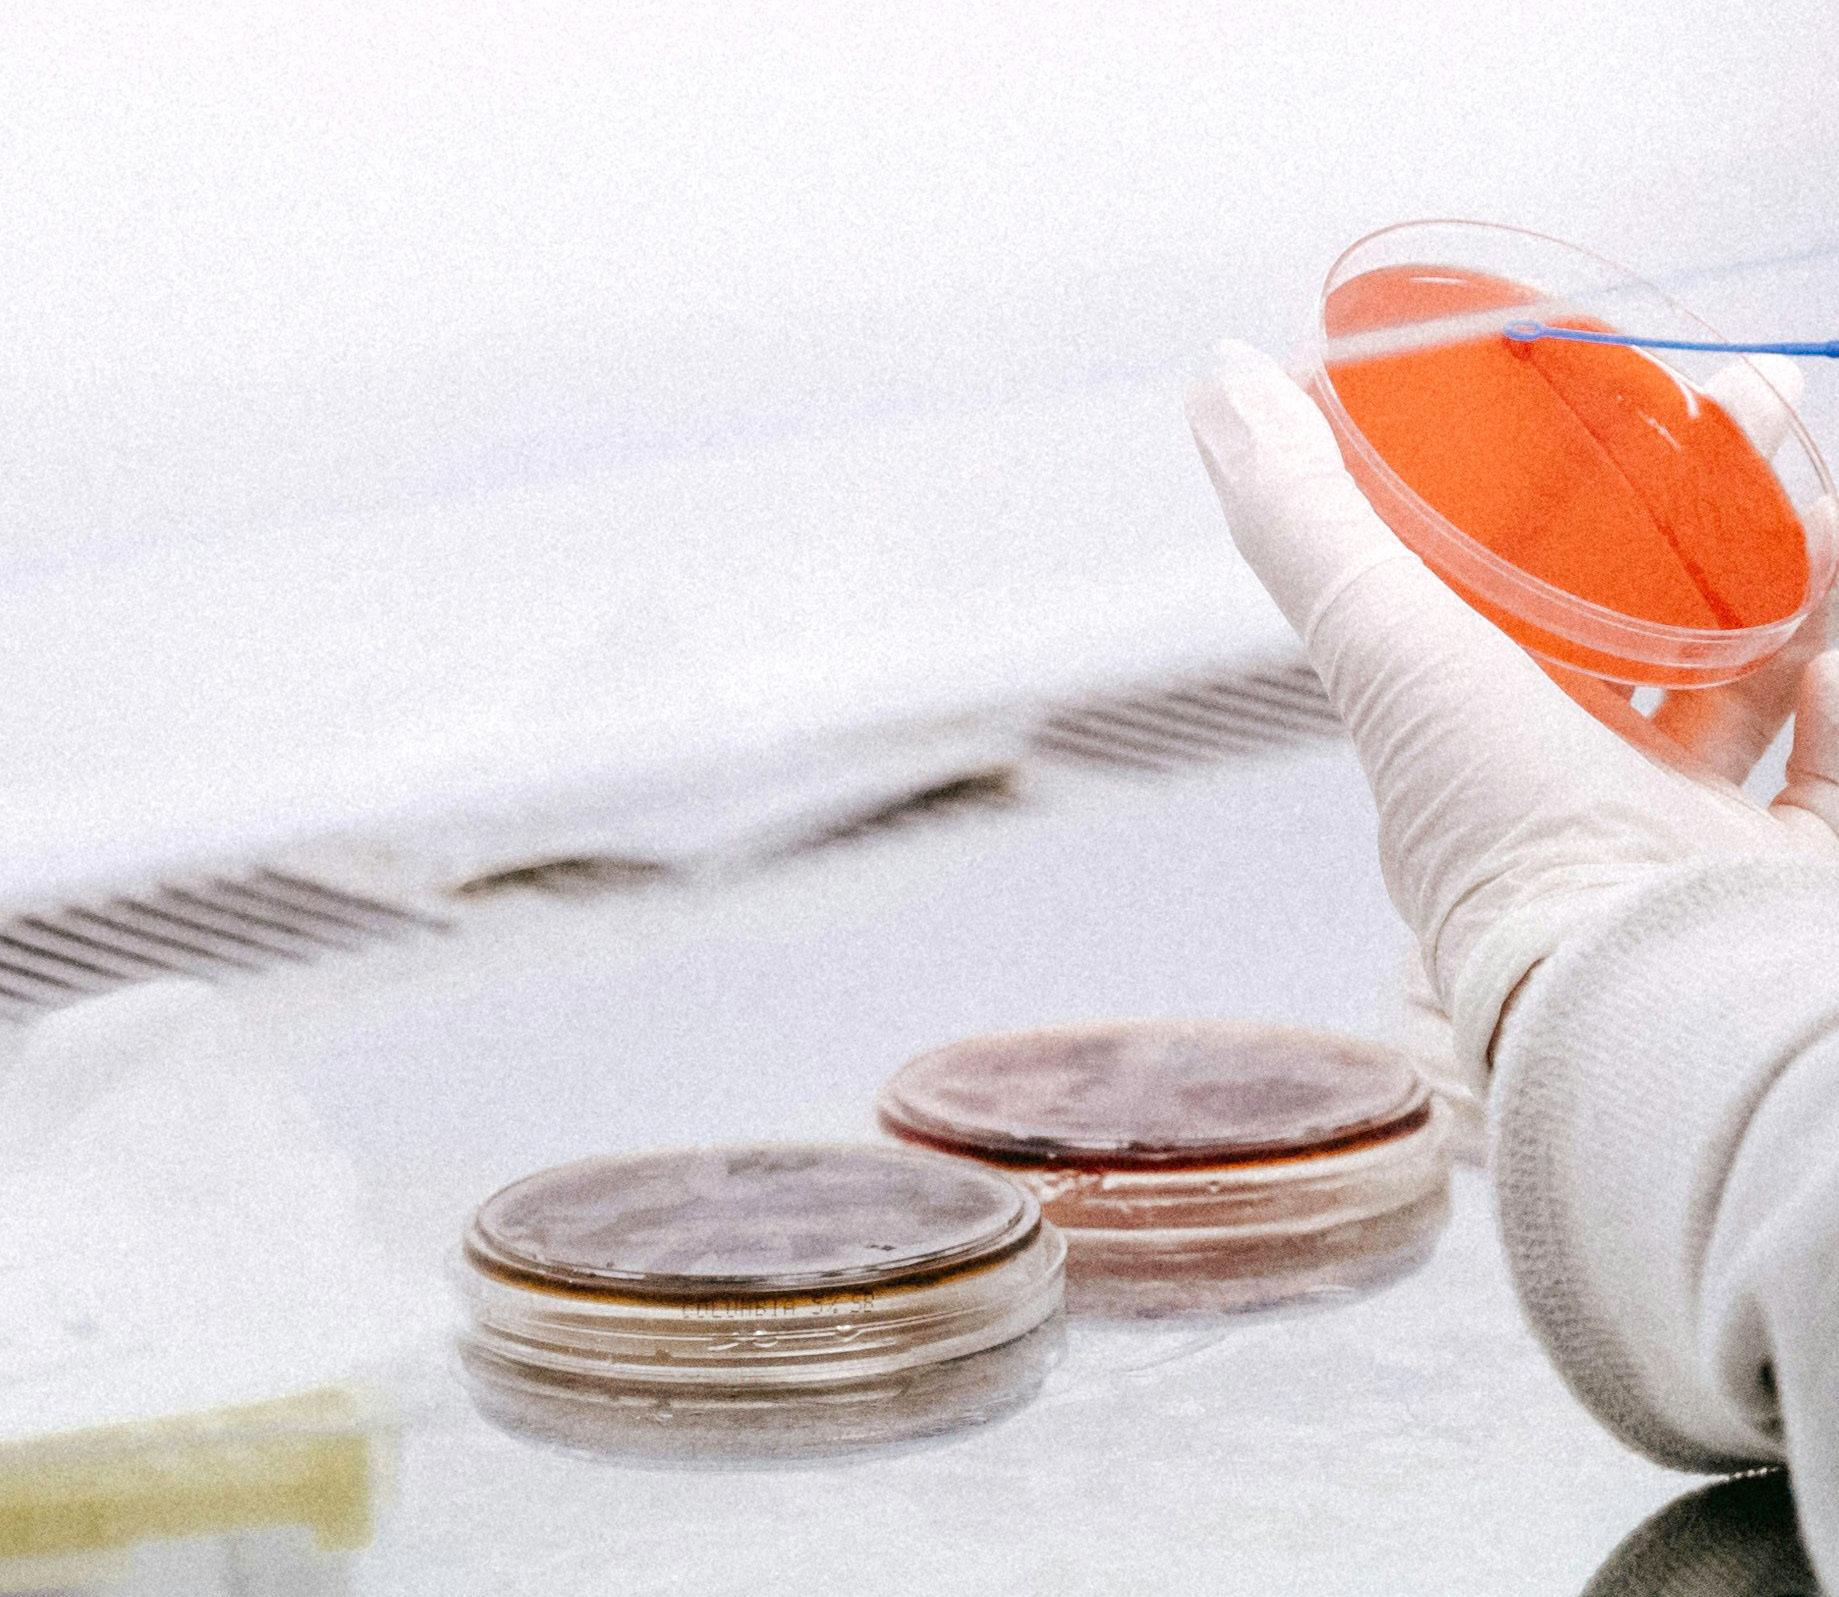

![]()




We had another big year at the NFXF! Off-conference years provide us with the chance to dig deeper into our strategic priorities, finding opportunities to expand our work and expand your access to invaluable resources and knowledge. Our team says over and over again that there is no one-size-fits-all approach to Fragile X, and we are determined to provide you with high-quality, relevant information and support that best fits your unique needs.
With that notion as our guide, we continued to offer meaningful programming while thoughtfully expanding our work. We hosted more webinars than ever on a
variety of topics, topics that were informed by your feedback, making 2023 our best-attended webinar series yet! We organized meetings covering crucial concepts, like succession planning and transition services within the Fragile X Clinical & Research Consortium and the status of outcome measures with the FDA, to encourage progress. We hosted 133 advocates from around the country at Advocacy Day and created quarterly newsletters so those and other Fragile X advocates have natural touch points with their Members of Congress, creating opportunities for yearround, continuous dialog. These programs, initiatives, and opportunities to connect strengthen the bonds within the Fragile X community, ensuring a brighter future for us all. But our work is far from finished.
We are still learning about the Fragile X premutationassociated conditions and what it means to age with Fragile X syndrome. We are still advocating for legislation that enables equality and access to important services for our loved ones with Fragile X and the broader communities we fall into. There are still no effective treatments for Fragile X, but there are many studies, trials, and researchers actively searching for options. And there are still people who need knowledge, resources, and tools to live their daily lives.
The National Fragile X Foundation plays an integral role in these spaces now and we know our role will be essential in the future. I am thrilled to know the National Fragile X Foundation will be there with you through it all. Thank you for the opportunity to work and play alongside you and your families, I look forward to seeing what’s in store!
Take care,

Hilary Rosselot, Executive Director
As we journey through another year, have you noticed the strides The National Fragile X Foundation has made in advancing our mission to serve the Fragile X community? I’m Laurie Bridges, your NFXF Board President, and I hope you have been noticing all the amazing work that was done in 2023!
Have you noticed Advocacy? The commitment to advocacy has continued to grow! We had an amazing Advocacy Day in Washington, DC. Our voices echoed through the halls (literally and sometimes loudly), advocating for policies and resources that benefit our community. Additionally, the advocacy newsletter is a source of information to help foster engagement.
Have you noticed Education? Education remains so important to our mission, and this year, the NFXF hosted many remarkable webinars, covering some important and meaningful topics. In addition, the Masterclass series for professionals and educators is also available and has been utilized by many to better support those living with Fragile X.
Have you noticed research? The NFXF is helping to support many studies going on all around the country. I’ve participated in 2 different studies this year involving those of us living with the Fragile X premutation. Significant progress is being made in supporting studies focused on the Fragile X premutation. Also, the NFXF Data Repository is being utilized and is helping the future of Fragile X treatment and care.
Have you noticed Treatment? Last October, I had the privilege of attending the Fragile X Clinic and Research Consortium meeting in person. Sitting in that room with this group of Xtraordinary professionals and watching them collaborate to improve outcomes for our families brought me to tears. It just reaffirmed to me the profound impact the NFXF has on supporting such amazing collaboration between our professionals.
It’s a privilege to serve in this role, witnessing firsthand how the NFXF embodies its mission to serve the entire Fragile X community.
As we continue this journey together, let’s look forward to 2024 including our conference in Orlando. It will be the

40th Anniversary of the Foundation so take notice and be a part of the difference we can make together!
In closing, I thank you for your continued support and dedication in helping The National Fragile X Foundation and all the families living with Fragile X. It’s not easy but together, we are making a difference and helping those affected by Fragile X to live their best lives.
Shine on and please come find me at Conference,

Laurie Bridges, Board President
Laurie Bridges President
Kara Frech Vice President
Jacquelyn Coleman
Peggy Flanigan
Joe Garera
Denny Haugen
Susan Howell
Tamaro Hudson, PhD
Jay Souder Ambassador
Anthony Fasciano Treasurer
Abby Gaunt Secretary
Rey Lozano, MD
Jed Seifert
Rebecca Shaffer, MD
Shari Silver
David Tillman
Victoria Wilkins, MD
Carolyn Tomberlin Ambassador
THANK YOU to our board members whose terms ended in 2023.
Anthony Fasciano | Joe Garera | Jed Seifert
WELCOME to this year’s new board members:
Jacquelyn Coleman
Peggy Flanigan
Susan Howell
Tamaro Hudson
David Tillman



We promote effective ways for families to successfully advocate for themselves and their children to meet the ongoing challenges of the Fragile X journey.
We provide valuable tools and resources to families to help manage the day-to-day challenges of life with Fragile X.


Improving Treatment
We seek to improve access and availability of informed treatment options to promote knowledge for all patients with Fragile X.
We facilitate research activities for families and professionals, underlining their value in the research process and how their active participation advances effective treatments and a cure.


$259,774


Our 133 advocates included self-advocates of all ages.
Over the past 19 years, NFXF advocates have aided in securing more than $500 million in federal funding for Fragile X research and programming and support for many legislative initiatives like the ABLE Act.
133
28 advocates representing states!
NIH-funded Fragile X Centers share their most up-to-date research on the Fragile X-associated conditions. Presented by Drs. Tracy King, Peng Jin, Peter Todd, and Craig Erickson
NIH representatives from each of the current NIH-funded Fragile X Centers of Excellence shared updates and answered questions about their progress to date.
• Dr. Tracy King Intellectual and Developmental Disabilities Branch of the National Institute of Child Health and Human Development
• Dr. Peng Jin Fragile X Center at Emory University
• Dr. Peter Todd University of Michigan Medical School, Baylor College of Medicine, and the Fragile X Center at Emory University
• Dr. Craig Erickson Cincinnati Children’s Hospital Medical Center
The updates began with a discussion on the purpose of the NIH and the importance of the Centers for Collaborative Research in Fragile X and FMR1-Related Conditions Program
Topics included preclinical (or non-human) models of Fragile X, potential treatments for Fragile X syndrome, FXTAS, FXPOI, and currently enrolling research studies.
Click here to read more about: Centers for Collaborative Research in Fragile X and FMR1-Related Conditions Program
The NIH Centers for Excellence work to support multidisciplinary, multi-institutional research to encourage the translation of basic research findings from bench to bedside and bedside to community. Every contribution makes an impact.
Watch the webinar





Promoting effective ways to advocate for the ongoing challenges of the Fragile X journey.
We began publishing a new quarterly “Fragile X Advocacy Newsletter” so advocates can stay updated yearround on the status of our asks, current letters of support, legislation already introduced, and upcoming legislation we are monitoring.
We encourage advocates to use the newsletters as a point of reference when working with their members of Congress throughout the year.

From picnics, to conferences, doctor’s appointments, to advocacy days, the NFXF has been by our side from the day we learned about our diagnosis. We are so grateful for all of the support on our journey.
More than a dozen relevant and dynamic panel discussions and Q&As with top experts.
We hosted a record number of webinars in 2023, all informed by you! We covered new topics and dove deeper into our most requested topics.
From January through December 2023, we covered:
• NIH Fragile X Centers of Excellence 2023 Update
Tracy King, Peng Jin, Peter Todd, and Craig Erickson
• Peer-Reviewed Medical Research Program’s FY 23
Funding Opportunities for Researchers
Kathryn Argue
• Females with FXS: Strategies for Developing
Executive Functioning and Social Skills
Barbara Haas-Givler
• Aging in Fragile X Syndrome
Elizabeth Berry-Kravis
• Housing Options for Adults With Fragile X Syndrome: Parents Share Their First-Hand Experiences – Part 2
Susan Buchanan, Nancy Carlson, Tracey Franks, and Ileen Rissmiller
• Educational Strategies for Success
Jeanine Coleman, Tracy Stackhouse, and Marcia Braden
• Reproductive Health (Puberty, Carrier Screening, and Reproductive Options and Family Planning)
Heather Hipp, Susan Howell, and Vicki Wilkins
• 2023 Industry Updates
Zynerba, Tetra, and Allos
• FORWARD-MARCH Update
Amie Milunovich, Liz Berry-Kravis, and Nicole Tartaglia
• Employment and Fragile X Syndrome
Jed and Darren Seifert; Paula, Ben, and Matty Fasciano; and Samantha Rhodes
• FXTAS Clinical & Research Q&A
Deborah Hall and Peter Todd
• Multidisciplinary Treatment of Fragile X Syndrome
Craig Erickson, Rebecca Shaffer, Kerri Chitwood, and Laura Hess
Through the years NFXF materials have helped tremendously in getting things included in my son’s IEP that educators would not have thought of as they did not know about Fragile X. We now enjoy participating in the webinars about different topics that affect him in adulthood, housing for example.



We heard from the community and are building up our Spanish language resources.
One of the things families, caregivers, and professionals asked for in the 2022 Community Survey last Fall was to have more resources available in Spanish. We have answered that request and now have several important resources available:
• Fragile X Fact Sheet
• Treatment Recommendations:
– Fragile X-Associated Tremor/Ataxia Syndrome
– Fragile X-Associated Primary Ovarian Insufficiency
– Behavioral Challenges in Fragile X Syndrome
– Medications in Fragile X Syndrome
As a reminder, we have more than 20 in-depth treatment recommendations reviewed by professionals from the Fragile X Clinical & Research Consortium. They are available to view online or download and we will be adding more of these in Spanish.
This organization has given our family so much knowledge about Fragile X and being a carrier. We feel like we belong to a very special community. “


The NFXF has provided essential training information in order for me to become a better teacher for my student with Fragile X syndrome.
Two new MasterClasses, by professionals, for professionals.




NFXF MasterClass™ — Fragile X 101 for Educators
Presented by Tracy Stackhouse and Marcia Braden
This two-part course provides an overview and discussion of Fragile X syndrome, the FXS learning style, and the relationship between FXS and autism, including strategies to support individuals throughout the lifespan.
NFXF MasterClass™ — Genetics of Fragile X
Presented by Susan Howell from the Colorado Children’s Hospital Fragile X Clinic, and Matthew Walsh from Emory University.
This course provides an overview of the genetics of Fragile X, including inheritance, indications for testing, the potential impact of the premutation and full mutation results, and resources to share with families.


Aditi Mahajan
The Electroretinogram and FMRP: Correlating Biomarkers for Fragile X Disorders
Aditi’s mentor: Randi J. Hagerman, MD, FAAP


Alexandra Singleton FXPOI Survey in Women’s Healthcare Providers
Alexandra’s mentor: Emily Allen, PhD


Maureen Butler
The Biological Basis of Pragmatic Language in Fragile X Premutation Carriers
Maureen’s mentor: Molly Losh, PhD

A readily available, inclusive repository.
We opened the NFXF Data Repository for query, and had our first request for use of data. The Data Repository is meant to facilitate research by building partnerships with credible researchers who can best utilize participants’ samples to make scientific advances for Fragile X.
Learn more about the NFXF Data Repository.
A family-friendly research summary of a powerful meeting of the minds working on the Fragile X premutation.
The 5 th International Conference on FMR1
Premutation covered a variety of important topics related to the Fragile X premutation, the recent progress in the field, and what we need to do to learn more and serve those with the Fragile X premutation.
Presenters ranged from researchers and clinicians to patient advocacy groups and family representatives. Conference attendees wrote an incredible paper summarizing these presentations, “Insight and Recommendations for Fragile X-Premutation-Associated Conditions,” and it happens to be almost 80 pages long!
So we created a family-friendly summary highlighting the most recent research and its clinical impact.

MINDInstitute,UniversityofCaliforniaDavis,Davis,CA95817,USA;bdoufour@ucdavis.edu(B.D.); drhessl@ucdavis.edu(D.H.);vmartinezcerdeno@ucdavis.edu(V.M.-C.) DepartmentofPharmacology,ClinicalPharmacologyandToxicology,FacultyofMedicine, UniversityofBelgrade,11129Belgrade,Serbia;dragana.protic@med.bg.ac.rs FragileXClinic,SpecialHospitalforCerebralPalsyandDevelopmentalNeurology,11040Belgrade,Serbia DepartmentofHumanGenetics,EmoryUniversitySchoolofMedicine,Atlanta,GA30322,USA; emily.g.allen@emory.edu(E.G.A.);peng.jin@emory.edu(P.J.);katharine.elizabeth.shelly@emory.edu(K.S.) VictorianClinicalGeneticsServices,RoyalChildren’sHospital,Melbourne,VIC3052,Australia; alison.archibald@vcgs.org.au NYSInstituteforBasicResearchinDevelopmentalDisabilities,NewYork,NY10314,USA DepartmentofPsychiatry,FragileXClinic,KennedyKriegerInstitute,Baltimore,MD21205,USA; budimirovic@kennedykrieger.org DepartmentofPsychiatry&BehavioralSciences-ChildPsychiatry,SchoolofMedicine,JohnsHopkinsUniversity, Baltimore,MD21205,USA FragileXAllianceClinic,Melbourne,VIC3161,Australia;jcohen@travelclinic.com.au DepartmentofPathologyandLaboratoryMedicine,InstituteforPediatricRegenerativeMedicine, ShrinersHospitalsforChildrenofNorthernCalifornia,SchoolofMedicine,UniversityofCaliforniaDavis, Sacramento,CA95817,USA;yamclennan@ucdavis.edu StemCellResearchLaboratory,MedicalGeneticsInstitute,ShaareZedekMedicalCenterAffiliatedwiththe NeuroscienceGraduateProgram,UniversityofMichigan,AnnArbor,MI48109,USA DepartmentofComputationalMedicineandBioinformatics,UniversityofMichigan,
Read the familyfriendly version of this important research.


Summarizing
work like this ensures research results get back to the people they are meant to serve.

Without
the right tools to measure change, we cannot prove that the investigational treatment is making a difference. These tools are called outcome measures.
What language development may look like for individuals with FXS.
The Fragile X Clinical & Research Consortium’s Treatment Recommendation covers language. While most individuals with FXS will develop spoken language at some point, there are typically global expressive or receptive language delays.
This is important information for parents, speechlanguage pathologists (SLP), occupational therapists (OT), and behaviorists.
Read Language in Fragile X Syndrome
Supporting individuals with FXS with their speech and language development is something that should be considered across the lifespan. Many of the strategies can be used regardless of age and are useful across a wide range of communication abilities.



Clinics in Pennsylvania and Utah expand the reach of FXCRC’s 40+ U.S. and international clinics.
We are thrilled to announce the addition of two new Fragile X syndrome clinics from Children’s Hospital of Philadelphia and the University of Utah and Primary Children’s Hospital.
The Fragile X Clinic at University of Utah and Primary Children’s Hospital is run by Dr. Victoria L. Wilkins, whose family lives with Fragile X. The team offers psychological testing and genetic counseling and support, and works with patients’ local teams to aid them in day-to-day management. Dr. Wilkins will see individuals ages 0 to 21.
The Specialty Care Center at Children’s Hospital of Philadelphia is run by developmental pediatrician Dr. Amanda Bennett who previously provided medical consultation and services to those utilizing the former Fragile X clinic in Elwyn, Pennsylvania. Dr. Bennett will see individuals ages 0 to 18. Visit the Fragile X clinic finder

— DR. AMANDA BENNETT “
The path is not often clear or easy, but no family should feel alone in the process.

Annual “FORE! Fragile X” Golf Event Raises over $250,000!
Jay and Anne Souder have hosted the annual golf event “FORE! Fragile X” since 2018 in honor of their son, Alec, who has Fragile X syndrome. Nearly 100 golfers and friends attended the 2023 event at Orange Tree Golf Course in Scottsdale, Arizona. Since 2018, the Souders and their friends have raised over $250,000 in support of the National Fragile X Foundation.


In the fall of 2023, the Schutz family did a generous and amazing thing. They shared their family’s story and offered a 1:1 match for donations up to $3,000 for an entire month.
The Souders have been active supporters of the NFXF since Alec, who is now in his mid30s, was diagnosed at 5-years-old. They know that the landscape of managing life with Fragile X is constantly changing and presents a unique set of challenges for parents and caregivers. Jay and Anne’s drive to organize a charity fundraiser comes from the desire to give hope to all families and to raise awareness and funds for the National Fragile X Foundation.
The NFXF has always been there for us, and we want to do everything we can to make sure that other families will benefit from their work as much as we have. — ANNE SOUDER

“We share our story in the hope that we can educate so many more people to understand what Fragile X Syndrome is, to raise both funds and awareness. The National Fragile X Foundation has become very important to us because it helps support families affected by Fragile X and FMR1-associated conditions and disorders every day, by promoting advocacy, providing education, advancing research, and improving treatments. In addition, Fragile X research benefits other conditions such as Alzheimer’s Disease, Parkinson’s Disease, Down Syndrome, Autism, and more.

“If not for the National Fragile X Foundation, we would
never have been exposed to a treatment for Wally that has so positively changed our family’s life.”
Read the full story, you’ll be glad you did.

Greater Chicago Fragile X chapter families gathered on a sunny day in November 2023 to support the Brookfield Zoo and its annual Tree Trim event while raising awareness for Fragile X. October 2023

The group hosts regular Zoom events including a nature occupational therapist discussing how to use all your senses while on a walk, and a Pilates instructor (and Fragile X mom) demonstrating how Pilates can be for anyone. September 2023

The NFXF Western Massachusetts Chapter held its 10th Cork & Cafe fundraising event. Nearly 60 people attended and enjoyed appetizers, wine tasting with 70 different wines, and a silent auction of 25 generously donated items. Thank you to Denise Devine, Sean Barry, volunteers, attendees, and donors!
September 24, 2023

Organized by Nancy and Ken Carlson and a team of dedicated volunteers and supporters, the NFXF Heartland Chapter (Iowa and South Dakota) hosted their 8th annual “Bike To X Out Fragile X” event that attracted more than 100 participants who helped raise awareness and funds for Fragile X.
June 3, 2023
Marner Family Hosts 4th Annual Quad Cities Fragile X Golf Outing
Andrea and Kevin Marner’s 4th annual golf event was the most successful yet! The 34 teams sold out the event and raised $12,000! Their new neighbors, Laco and Anna Marquez, not only donated an amazing food spread, but they prepared and served it too!
The Marners — and the NFXF— thank their sponsors for making the event possible: MH Equipment, Blaze Restoration, Heritage Landscape Design, Sacco’s Family Properties, Evans Concrete and Excavating, Marquez Family, Russell Family, Wiegel Family, Wicked Stitches, Mark Carlson, and Jeff Murphy.


The golf outing has also connected the Fragile X community in our area. Our son Reid met another young man with Fragile X named Eli, whose family and friends came in support by creating four teams this year, led by his parents Chad and Julie. — KEVIN MARNER



The Fragile X on the Farm fundraising event was made possible by Maryland Fragile X families pooling their resources. The fun and informative night included presenters Hilary Rosselot, NFXF Executive Director, Wen Huang and Ingrid Bell, parents of children with Fragile X syndrome, and Drs. Paul and Randi Hagerman, University of California, Davis MIND Institute professors. There were also games, picture-taking, whiskey tasting, and a performance by the Wootton High School live jazz band.
Parent organizer and NFXF board member Tamaro Hudson thanks all attendees and supporters who helped raise more than $13,000!

The Annual Autism Connections Conference, held April 10, 2024, in Springfield, Mass., brought professionals and families together to learn more about autism and how to adopt strategies and therapies to help someone they know with autism.
NFXF Western Massachusetts Chapter leader Denise Devine attended this year’s conference and came ready to educate and raise awareness about Fragile X. Denise handed out information and was on hand to talk with anyone interested in learning more about the similarities between Fragile X syndrome and autism, testing, and how research in both areas can benefit Fragile X and autism.
Western MA Chapter Host’s 8th Annual Hadley Cornhole Championship
The 8th Annual Hadley Corn Hole Championship, organized by the Western Massachusetts Fragile X chapter on March 3, 2024, marked a day of camaraderie, spirited competition, and impactful fundraising. This not-to-bemissed event brought together 26 competitive teams and an estimated 150 attendees from the community, resulting in an impressive $4,000 raised to support Fragile X awareness and research.


The NFXF Greater Chicago Chapter organized a night out in Arlington Heights, Ill., with delicious food, shared experiences, and discussed challenges and strategies. September 9, 2023
It was the best turnout we have had!
— DAWN BROWN, Chapter Leader

The NFXF Connecticut Chapter hosted a family pool party for families from Connecticut, Rhode Island, and Massachusetts. Guests from 2 to 92-years-old enjoyed perfect weather, pool games, good food, and great connections. August 13, 2023
A total of 45 raffle prizes were up for grabs for the price of a ticket. The competitive spirit of the tournament proved to be the perfect platform for socializing with old and new friends, and of course, contributed to reaching fundraising goals.

Thank you to the over 800 registrants and donors from across the country who participated in X Strides 2023 during Fragile X Awareness Month. Fragile X knows no racial or economic bounds. Because of you, the NFXF can further our mission of serving the entire Fragile X community to live their best lives by providing the knowledge, resources, and tools until, and even after, more effective treatments and a cure are achieved. Together, We’re Stronger!

The NFXF Western Massachusetts and Connecticut chapters and the Sibling & Self-Advocate Network had an evening out with new and familiar faces. September 28, 2023




After three years of hosting events online, the NFXF Western Massachusetts and Connecticut chapters organized an evening out for moms, siblings, and self-advocates. Connecticut chapter leader Tammy Selinger, said, “It was exciting to be back in-person and the evening was wonderful!” March 2023





























































































Hilary Rosselot Executive Director hilary@fragilex.org

Missy Zolecki Director, Community Empowerment missy@fragilex.org

Jaleesa Holden Special Projects Contractor jaleesa@fragilex.org

Kristin Bogart Senior Director, Development and Communications kristin@fragilex.org

Kim Toman Director of Operations kim@fragilex.org

Amie Milunovich FORWARD National Coordinator amie@fragilex.org

Anna De Sonia Director, Research Facilitation adesonia@fragilex.org

Robby Miller Director, Clinic and International Relations robby@fragilex.org

Mandie Rush Development Assistant mrush@fragilex.org
